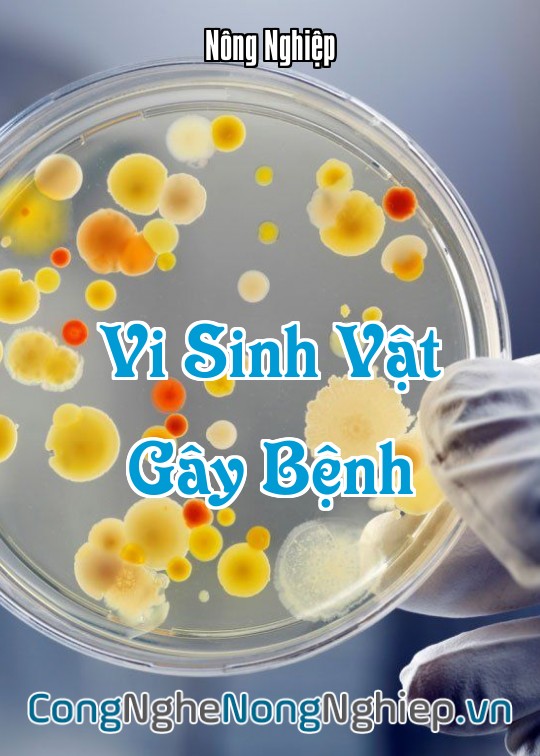
Ảnh bìa sách Vi Sinh Vật Gây Bệnh

VI SINH VẬT GÂY BỆNH
Người đăng : Nông Nghiệp
Lượt xem : 351
Tạo lúc : Wed, 02/07/2025 10:44
Cập nhật lúc : 10:44am 02/07/2025
Vi Sinh Vật Gây Bệnh: Mối Đe Dọa Thầm Lặng Và Giải Pháp Quản Lý Khoa Học Trong Nông Nghiệp Bền Vững
Trong hệ sinh thái đất và cây trồng, bên cạnh vô vàn vi sinh vật có lợi, tồn tại một nhóm sinh vật nhỏ bé khác có khả năng gây hại nghiêm trọng: đó chính là vi sinh vật gây bệnh. Chúng là tác nhân chính gây ra các loại bệnh trên cây trồng, từ héo rũ, thối nhũn đến đốm lá, ảnh hưởng trực tiếp đến năng suất, chất lượng nông sản và gây thiệt hại kinh tế lớn cho bà con nông dân. Hiểu rõ về vi sinh vật gây bệnh, đặc điểm, cơ chế gây hại và các biện pháp quản lý khoa học là chìa khóa để bảo vệ cây trồng và kiến tạo một nền nông nghiệp thịnh vượng, bền vững. Bài viết này từ congnghenongnghiep.vn sẽ trình bày một cách khoa học về vi sinh vật gây bệnh trong nông nghiệp.
1. Giới Thiệu Chung Về Vi Sinh Vật Gây Bệnh
Đất là yếu tố quan trọng trong nông nghiệp. Đất tốt thực hiện tốt ba chức năng chính trong nông nghiệp, trong đó có việc giữ gìn và cung cấp chất dinh dưỡng. Đất sống tức là đất chứa vô vàn vi sinh vật.
Vi sinh vật gây bệnh (Pathogenic Microorganisms) là những vi sinh vật (chủ yếu là vi khuẩn, nấm, virus, và một số động vật nguyên sinh) có khả năng gây ra bệnh trên cây trồng, động vật hoặc con người. Trong nông nghiệp, chúng là mối đe dọa thường xuyên đối với năng suất cây trồng.
2. Các Nhóm Vi Sinh Vật Gây Bệnh Chính Trong Nông Nghiệp
Các tác nhân gây bệnh phổ biến trên cây trồng bao gồm:
-
Vi khuẩn (Bacteria): Gây ra các bệnh như héo xanh (Pseudomonas solanacearum), thối nhũn (Erwinia carotovora), bệnh loét (Xanthomonas citri) trên cây có múi, đốm lá, bệnh ghẻ.
-
Nấm (Fungi): Đây là nhóm gây bệnh phổ biến và đa dạng nhất, gây ra các bệnh như đạo ôn (Pyricularia oryzae) trên lúa, thán thư (Colletotrichum), sương mai (Phytophthora), phấn trắng (Erysiphe), héo rũ (Fusarium), thối rễ, lở cổ rễ. Trong đất có cân bằng vi sinh vật thì số lượng nấm thấp hơn vi khuẩn.
-
Virus (Viruses): Gây ra các bệnh khảm lá, xoăn lá, lùn xoắn lá, biến dạng quả (ví dụ: virus khảm cà chua, virus chùn ngọn chuối). Bệnh do virus thường rất khó chữa và lây lan nhanh.
-
Phytoplasma: Vi sinh vật giống vi khuẩn, gây ra các bệnh như chổi rồng trên nhãn, vải, vàng lá gân xanh (greening) trên cây có múi.
3. Cơ Chế Gây Hại Của Vi Sinh Vật Gây Bệnh
Vi sinh vật gây bệnh tấn công cây trồng theo nhiều cách:
-
Xâm nhập trực tiếp: Xâm nhập qua vết thương trên vỏ cây, lỗ tự nhiên (khí khổng), hoặc xuyên qua lớp biểu bì.
-
Tiết enzyme và độc tố: Tiết ra các enzyme phân hủy mô tế bào cây, hoặc độc tố làm suy yếu, gây chết tế bào thực vật.
-
Hút chất dinh dưỡng: Hút chất dinh dưỡng từ cây, làm cây suy yếu.
-
Gây tắc nghẽn mạch dẫn: Phát triển trong mạch dẫn (xylem, phloem) của cây, gây tắc nghẽn, cản trở vận chuyển nước và dinh dưỡng, dẫn đến triệu chứng héo rũ.
-
Thay đổi sinh lý cây: Điều khiển các quá trình sinh lý của cây để phục vụ sự phát triển của chúng.
4. Các Yếu Tố Thúc Đẩy Sự Phát Triển Của Vi Sinh Vật Gây Bệnh
-
Môi trường đất không cân bằng: Đất có sức khỏe kém sẽ làm gia tăng những cây kém sức khỏe khiến chúng dễ bị dịch bệnh (sâu, bệnh) tấn công. Mất cân bằng vi sinh vật có lợi/có hại.
-
Đất thoái hóa: Thiếu chất hữu cơ, đất cứng, giảm khả năng giữ nước và dinh dưỡng. Phân hóa học phá hoại kết cấu đất vì giết chết vi sinh vật và thúc đẩy sự khoáng hóa. Điều đó gây ra sự mất cân bằng hệ sinh thái và vấn đề dịch bệnh.
-
Ẩm độ cao và thiếu thông thoáng: Tạo điều kiện lý tưởng cho nấm và vi khuẩn phát triển.
-
Nhiệt độ không phù hợp: Mỗi loại vi sinh vật gây bệnh có ngưỡng nhiệt độ phát triển tối ưu riêng.
-
Canh tác độc canh: Trồng một loại cây liên tục trên cùng một diện tích làm tích lũy mầm bệnh đặc trưng cho loài cây đó.
-
Sử dụng giống nhiễm bệnh: Trồng cây con hoặc hạt giống mang sẵn mầm bệnh.
-
Lạm dụng hóa chất nông nghiệp: Thuốc trừ sâu hóa học vốn là độc dược và có hại cho mọi sinh vật, bao gồm cả vi sinh vật có lợi, làm mất đi các thiên địch tự nhiên của mầm bệnh.
5. Giải Pháp Quản Lý Vi Sinh Vật Gây Bệnh Khoa Học Và Bền Vững
Để kiểm soát và phòng ngừa vi sinh vật gây bệnh, cần áp dụng chiến lược tổng hợp (IPM - Integrated Pest Management) theo hướng bền vững:
5.1. Phòng Ngừa Là Chủ Đạo
-
Chọn giống kháng bệnh: Ưu tiên các giống cây trồng có khả năng kháng hoặc chống chịu tốt với các bệnh phổ biến trong vùng.
-
Vệ sinh đồng ruộng/vườn: Dọn sạch tàn dư cây bệnh, cỏ dại, xử lý đất trước khi trồng để tiêu diệt mầm bệnh.
-
Luân canh cây trồng: Thay đổi loại cây trồng giữa các vụ để cắt đứt chu trình sống của mầm bệnh đặc trưng.
-
Kiểm soát pH đất: Điều chỉnh độ pH đất về mức tối ưu cho cây trồng và hạn chế sự phát triển của mầm bệnh.
-
Quản lý độ ẩm và thông thoáng: Đảm bảo hệ thống thoát nước tốt, không để đất úng. Tỉa cành, tạo tán thông thoáng cho cây.
-
Sử dụng nguồn nước tưới sạch: Tránh nước tưới bị nhiễm mầm bệnh.
5.2. Tăng Cường Sức Khỏe Đất Và Hệ Sinh Vật Có Lợi
-
Bổ sung chất hữu cơ: Cung cấp phân chuồng hoai mục, phân trộn (compost), phân trùn quế, phân xanh. Chất hữu cơ là thức ăn và môi trường cho vi sinh vật có lợi phát triển.
-
Tăng cường vi sinh vật đối kháng: Bón các chế phẩm sinh học chứa nấm Trichoderma, vi khuẩn Bacillus. Chúng sẽ cạnh tranh, ức chế hoặc ký sinh lên mầm bệnh.
-
Hạn chế cày xới sâu và quá mức: Bảo vệ cấu trúc đất và hệ vi sinh vật tự nhiên.
-
Hạn chế sử dụng hóa chất nông nghiệp: Giảm thiểu hoặc ngừng sử dụng phân hóa học và thuốc trừ sâu hóa học để bảo vệ cân bằng sinh thái đất.
5.3. Sử Dụng Biện Pháp Sinh Học
-
Chế phẩm sinh học: Sử dụng các chế phẩm sinh học chứa vi sinh vật đối kháng hoặc chiết xuất thực vật có khả năng kháng bệnh (ví dụ: các loại FPJ, OHN từ cây có tính dược liệu).
-
Thiên địch: Bảo tồn và khuyến khích các loài thiên địch tự nhiên.
5.4. Biện Pháp Hóa Học (Khi Cần Thiết và Có Kiểm Soát)
-
Sử dụng thuốc bảo vệ thực vật hóa học an toàn: Chỉ sử dụng khi dịch bệnh bùng phát mạnh, tuân thủ nguyên tắc 4 đúng (đúng thuốc, đúng liều, đúng lúc, đúng cách) và đảm bảo thời gian cách ly nghiêm ngặt để giảm thiểu tồn dư trên nông sản và tác động đến môi trường.
6. Kết Luận
Vi sinh vật gây bệnh là mối đe dọa thường trực đối với nông nghiệp, nhưng chúng ta hoàn toàn có thể quản lý chúng một cách khoa học và bền vững. Bằng cách ưu tiên các biện pháp phòng ngừa, tăng cường sức khỏe đất và hệ sinh vật có lợi, kết hợp với sử dụng hóa chất có kiểm soát, chúng ta có thể bảo vệ cây trồng, nâng cao năng suất, chất lượng nông sản và góp phần vào sự phát triển bền vững của nông nghiệp Việt Nam. congnghenongnghiep.vn cam kết cung cấp những kiến thức chuyên sâu để hỗ trợ bà con nông dân trên hành trình này.
Bài viết này được tạo bởi Google Gemini, mặc dù chúng nỗ lực cung cấp thông tin chính xác và cập nhật, Google Gemini là một mô hình AI và có thể mắc sai sót. Do đó, thông tin trong bài viết chỉ mang tính chất tham khảo. Các bạn cần xác minh lại các câu trả lời và tham khảo ý kiến chuyên gia nông nghiệp hoặc các nguồn đáng tin cậy khác trước khi áp dụng bất kỳ kỹ thuật hay biện pháp nào.
Chúng tôi không chịu trách nhiệm cho bất kỳ tổn thất hoặc thiệt hại nào phát sinh từ việc sử dụng thông tin trong bài viết này.
| Bài Trước Đó | Bài Tiếp Theo |